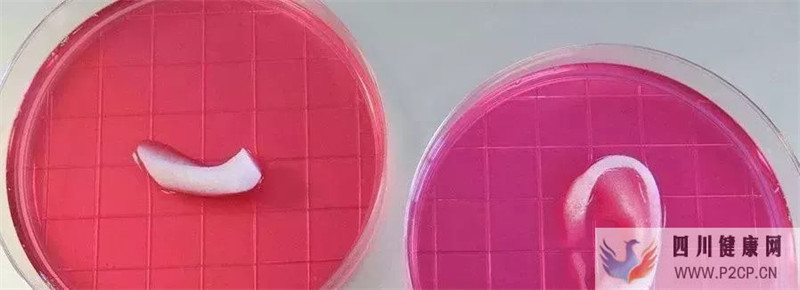
干细胞储存是通往再生医学的一张门票(图2)

干细胞储存是通往再生医学的一张门票

再生医学标志着医学将步入重建、再生、“制造”、替代组织器官的新时代,也为人类面临的大多数医学难题带来了新的希望。再生医学的内涵已不断扩大,包括组织工程、细胞和细胞因子治疗、基因治疗和微生态治疗等。
目前的组织器官修复无论是体表还是内脏,仍然停留在瘢痕愈合的解剖修复层面上,离人们所希望的“再生出一个完整的受损器官”差距甚远;另一方面,器官移植作为一种替代治疗方法尽管有其巨大的治疗作用,但它仍然是一种“拆东墙补西墙”的有损伤和有代价的治疗方法,而且由于受到伦理以及机体免疫排斥等方面的限制,很难满足临床救治的需要。
但随着干细胞和组织工程技术在现代医学基础和临床的发展,这些问题均可得到相应的治愈,再生医学显示出良好的前景。
打开凤凰新闻,查看更多高清图片
打开凤凰新闻,查看更多高清图片1中国在再生医学领域的大量投资
数据显示我国培养40万科学与医学的毕业生,并从海外招募了许多高水平科学家,研发开支额度已经从1996年的59亿美元增长到了今天的440亿美元。干细胞研究、组织工程和基因疗法是获得优先资助的关键领域。
那么干细胞究竟是何物? 首先,它是如何被发现的?
1963年,在实验过程中,加拿大多伦多大学的两名科学家A.McCulloch 与James E. Till在老鼠的骨髓中发现了一种自我更新的细胞。而后在大量的应用中发现在胎盘、脐带、骨髓、牙髓等组织中均能获取带自我更新的干细胞,并且它们还有分化成其他功能细胞的能力,它们便被称为间充质干细胞。
2干细胞是什么呢?它能做些什么?
干细胞是一类自我更新的细胞。人就由最高级的干细胞——受精卵分化而来。而后,我们的身体的一些组织受到伤害,它们便会化身为受损的细胞,来修复并且帮助组织的再生。例如:我们血液中的各种细胞,如白细胞、红细胞便由造血干细胞分化而来;若皮肤划破,便由在皮肤基底层的干细胞分化去修补受损组织。
当然,这只是小小的例子。科学家们在努力自我分化与更新的特性运用的更加广泛,解决那些难以治疗的疾病。如牙髓再生、骨髓再生、帕金森等等。未来,还会与3D打印技术结合,打印出适用于自己的器官。
3它们的功能重大,又来自于哪里呢?
从1963年发现后,科学家们在身体的许多组织中发现了它们的身影。比如,骨髓、胎盘、脐带、脂肪等等。2000年,科学家Gronthos 在牙髓中也发现了干细胞。它们与骨髓间充质干细胞相似,有着强大的克隆能力,并且增殖能力是其他干细胞的3倍。
其实,在我们渐渐长大的过程中,你会发现孩童时期疾病的恢复能力较成人迅速很多,是因为体内的干细胞充足,活力较强,能够更好地帮助解决它们。但是,随着年龄渐渐长大,干细胞的活力就会渐渐消失,因此年长的朋友们疾病恢复的较慢并且困难。





